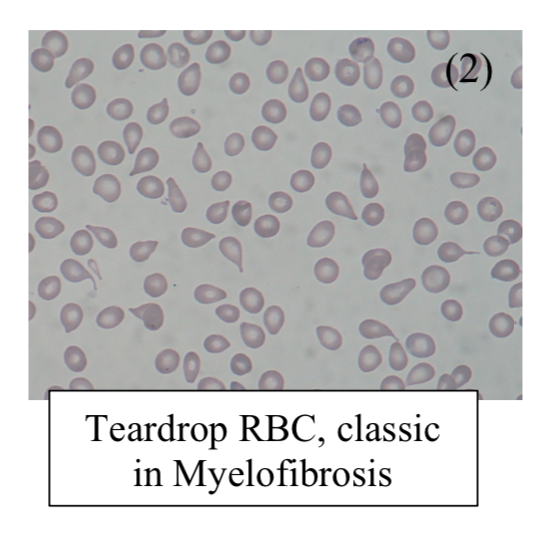

Back to: Haematology
Myeloproliferative Disorders
This is a neoproliferation of mature cells of the myeloid lineage – it is a disease of late adulthood
– Cells of all myeloid lineages are increased but the disease is classified based on main cell type produced.
– They are associated with mutations in JAK2 kinase
– Main complications are risk of ↑ uric acid (gout) due to high cell turnover, bone marrow fibrosis and progression to an acute leukaemia.
Polycythaemia Vera (RBC)
This is a proliferation of RBCs, which are unusual as they do not require erythropoietin to survive
– Almost all of these patients have a JAK2 kinase mutation and it commonly presents after the age of 60
– There is also excess WBCs and platelets, which leads to hyperviscosity and thrombosis.
Symptoms:
– Headaches, blurry vision and dizziness + Hypertension
– Itching after hot bath (due to histamine release from more mast cells)
– Flushed face due to congestion
– Splenomegaly
– Venous (DVT) and arterial (MI) thrombosis
Diagnosis:
FBC shows increased hematocrit + Mutation in JAK2
– It is possible to get a diagnosis if JAK2 negative but requires more features
e.g. Raised RBC mass on 51Cr Studies with splenomegaly with normal PaO2 is diagnostic
Management:
– 1st line is phlebotomy, aim to keep hematocrit <0.45 to reduce risk of thrombosis + Aspirin
– 2nd line is hydroxyurea –> inhibits ribonucleotide reductase
– If left untreated, it can progress to myelofibrosis or an acute leukaemia
N.B. You can get other types of polycythemia which are not associated with a Jak2 Kinase mutation
Other types of polycythaemia
i) Relative polycythemia
This is where reduced blood plasma causes an apparent rise in erythrocyte levels in the blood.
– Red cell mass studies are used to differentiate between relative and true polycythemias.
– In true polycythemia the total red cell mass in males is >35ml/kg and females >32ml/kg
Causes: Dehydration, Stress, Burns
ii) Secondary Polycythemia
This is a a rise in erythrocyte level due to EPO production due to secondary causes
Causes: COPD, altitude, sleep apnea, hypernephroma
Essential Thrombocythaemia (Platelet)
This is a proliferation of platelets >600 x 109/L with abnormal function, causing bleeding or thrombosis.
– Raised platelets can be a reactive condition due to bleeding, infection, malignancy or iron deficiency anaemia.
– These should be ruled out to give a diagnosis of essential thrombocythemia
Symptoms:
These are due to higher chance of bleeding and/or thrombosis
– Microvascular occlusion –> headache, chest pain + light-headedness
– Burning sensation in the hands is characteristic
Tests:
– FBC shows anaemia and raised WCC and platelet + JAK2 mutation
Management:
– Low dose Aspirin
– Hydroxyurea reduces platelet count
– Interferon-a for younger patients

Myelodysplasia
This is an acquired neoproliferation of haematopoietic stem cells
– Presents with bone marrow failure and more common as you get older
– It is low-grade and may progress to AML.
Myelofibrosis (Megakaryocytes)
This is a proliferation of abnormal megakaryocytes which produce plate-derived growth factor (PDGF)
– This is thought to stimulate fibroblasts and lead to intense bone marrow fibrosis, meaning the spleen and liver must make RBCs instead, usually seen in the elderly
Symptoms:
– Anaemia (pale, tired, lethargic)
– Constitutional symptoms –> fever, weight loss, night sweats
– Gives massive splenomegaly due to extramedullary hematopoiesis
Tests:
FBC shows anaemia but high WBC and platelet count
– Blood film shows teardrop poikilocytes
– Trephine biopsy is needed as you cannot get an aspirate
– Raised urate and LDH levels
Management:
Bone marrow support with RBC and Platelet transfusion
Sources
Image 1: Prof. Osaro Erhabor, CC BY-SA 4.0 <https://creativecommons.org/licenses/by-sa/4.0>, via Wikimedia Commons
Image 2: Paulo Henrique Orlandi Mourao, CC BY-SA 3.0 <https://creativecommons.org/licenses/by-sa/3.0>, via Wikimedia Commons


